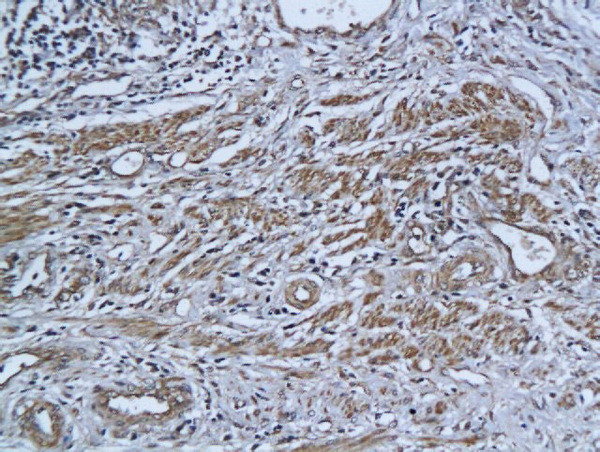
ADAR1 Antibody in Immunohistochemistry (Paraffin) (IHC (P))

Search
Bioss
ADAR1 Polyclonal Antibody
{{$productOrderCtrl.translations['antibody.pdp.commerceCard.promotion.promotions']}}
{{$productOrderCtrl.translations['antibody.pdp.commerceCard.promotion.viewpromo']}}
{{$productOrderCtrl.translations['antibody.pdp.commerceCard.promotion.promocode']}}: {{promo.promoCode}} {{promo.promoTitle}} {{promo.promoDescription}}. {{$productOrderCtrl.translations['antibody.pdp.commerceCard.promotion.learnmore']}}
产品信息
BS-2167R
种属反应
宿主/亚型
分类
类型
抗原
偶联物
形式
浓度
规格
纯化类型
保存液
内含物
保存条件
运输条件
靶标信息
Adenosine Deaminase RNA Specific (ADAR) catalyzes the hydrolytic deamination of adenosine to inosine in double-stranded RNA (dsRNA) referred to as A-to-I RNA editing.This may affect gene expression and function in a number of ways that include mRNA translation by changing codons and hence the amino acid sequence of proteins; pre-mRNA splicing by altering splice site recognition sequences; RNA stability by changing sequences involved in nuclease recognition; genetic stability in the case of RNA virus genomes by changing sequences during viral RNA replication; and RNA structure-dependent activities such as microRNA production or targeting or protein-RNA interactions. ADAR can edit both viral and cellular RNAs and can edit RNAs at multiple sites (hyper-editing) or at specific sites (site-specific editing). Its cellular RNA substrates include: bladder cancer-associated protein (BLCAP), neurotransmitter receptors for glutamate (GRIA2) and serotonin (HTR2C) and GABA receptor (GABRA3). Site-specific RNA editing of transcripts encoding these proteins results in amino acid substitutions which consequently alters their functional activities. Exhibits low-level editing at the GRIA2 Q/R site, but edits efficiently at the R/G site and HOTSPOT1. Its viral RNA substrates include: hepatitis C virus (HCV), vesicular stomatitis virus (VSV), measles virus (MV), hepatitis delta virus (HDV), and human immunodeficiency virus type 1 (HIV-1). Exhibits either a proviral (HDV, MV, VSV and HIV-1) or an antiviral effect (HCV) and this can be editing-dependent (HDV and HCV), editing-independent (VSV and MV) or both (HIV-1). Impairs HCV replication via RNA editing at multiple sites. Enhances the replication of MV, VSV and HIV-1 through an editing-independent mechanism via suppression of EIF2AK2/PKR activation and function. Stimulates both the release and infectivity of HIV-1 viral particles by an editing-dependent mechanism where it associates with viral RNAs and edits adenosines in the 5'UTR and the Rev and Tat coding sequence. Can enhance viral replication of HDV via A-to-I editing at a site designated as amber/W, thereby changing an UAG amber stop codon to an UIG tryptophan (W) codon that permits synthesis of the large delta antigen (L-HDAg) which has a key role in the assembly of viral particles. However, high levels of ADAR1 inhibit HDV replication. (Uniprot)
仅用于科研。不用于诊断过程。未经明确授权不得转售。
篇参考文献 (0)
生物信息学
蛋白别名: 136 kDa double-stranded RNA-binding protein; ADA; ADAR1; Adenosine Deaminase; adenosine deaminase acting on RNA 1-A; Double-stranded RNA-specific adenosine deaminase; DRADA; dsRNA adenosine deaminase; dsRNA adeonosine deaminase; IFI-4; interferon-induced protein 4; Interferon-inducible protein 4; K88DSRBP; p136; unnamed protein product
基因别名: ADAR; ADAR1; AGS6; DRADA; DSH; DSRAD; G1P1; IFI-4; IFI4; K88DSRBP; P136
UniProt ID: (Human) P55265
Entrez Gene ID: (Human) 103